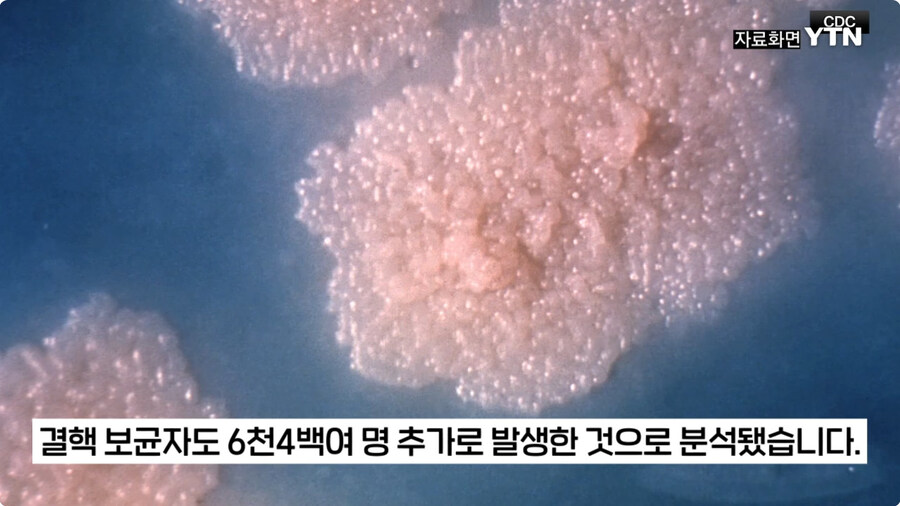
도람푸랑 머스크가 낭비라고 생각하면서 죽여버린거_6.jpg

[{"keyword":"\uc5d4\ub4dc\ud544\ub4dc","rank":0},{"keyword":"\ube14\ub8e8\uc544\uce74","rank":1},{"keyword":"\ud2b8\ub9ad\uceec","rank":-1},{"keyword":"\ub864","rank":2},{"keyword":"\ubc84\ud29c\ubc84","rank":0},{"keyword":"\ub9bc\ubc84\uc2a4","rank":-2},{"keyword":"\u3147\u3147\u3131","rank":1},{"keyword":"\ub2c8\ucf00","rank":5},{"keyword":"\uba85\uc870","rank":0},{"keyword":"\ud398\uc774\ud2b8","rank":12},{"keyword":"\uc6d0\uc2e0","rank":-1},{"keyword":"\uc8fc\uc220\ud68c\uc804","rank":3},{"keyword":"\ucc28\uc740\uc6b0","rank":-6},{"keyword":"\uce74\uad6c\uc57c","rank":-2},{"keyword":"\uac74\ub2f4","rank":3},{"keyword":"\ub358\ud30c","rank":-2},{"keyword":"\uc8fc\uc220","rank":-1},{"keyword":"\uc820\ub808\uc2a4","rank":"new"},{"keyword":"@","rank":-2},{"keyword":"\uc5d4\ub4dc","rank":1},{"keyword":"\ub9d0\ub538","rank":-10},{"keyword":"\ub958\uc73c\ubbf8","rank":"new"}]

(IP보기클릭)118.235.***.***
전염병에 대한 구제는 지원도 복지도 아님 저 사람들이 자국민한테 퍼트리는걸 미연에 방지하는 사전조치일뿐이다 이걸 모르는 대갈텅텅이 존나존나존나 많아 진짜 ㅋㅋㅋ
(IP보기클릭)125.143.***.***
미국인척결 다섯글자에 환호성 역시 정상화는 대럼프
(IP보기클릭)106.101.***.***
미국인은 까다로운 "선택"을 하게 될 겁니다
(IP보기클릭)110.10.***.***
코로나보다 쎈거 온다는데 그거 오면 미국 매드맥스 찍고있을듯
(IP보기클릭)221.144.***.***
그러니까 줘까타도 세계경찰이다 뭐다 하면서 떠받들여준거지
(IP보기클릭)118.235.***.***
미국인이 복지를 논한다고...?
(IP보기클릭)124.63.***.***
이런거 보니깐 진짜 미국애들이 많은걸 하고 있었네
(IP보기클릭)106.101.***.***
미국인은 까다로운 "선택"을 하게 될 겁니다
(IP보기클릭)211.235.***.***
이제 선택 없는거 아냐? 도람프 종신대통령 된다던데 ㅋㅋ | 25.03.11 20:28 | | |
(IP보기클릭)125.143.***.***
미국인척결 다섯글자에 환호성 역시 정상화는 대럼프
(IP보기클릭)14.33.***.***
드디어 대럼프가 미합중국 정상화하네 | 25.03.11 20:30 | | |
(IP보기클릭)106.102.***.***
이렇게 박멸 직전의 전염병들 막 돌고 돌아서 무식하거나 음모론에 심취해서 백신 안 맞는 인간들 대충 병걸려 죽어서 추려지고나면 다시 미국 정치가 정상화될 듯. 과거에는 전쟁이 하던 인구조절 기능을 요즘은 판데믹이나 자연재해가 하게 될 듯. | 25.03.11 20:39 | | |
(IP보기클릭)110.10.***.***
코로나보다 쎈거 온다는데 그거 오면 미국 매드맥스 찍고있을듯
(IP보기클릭)112.185.***.***
(IP보기클릭)211.246.***.***
(IP보기클릭)118.235.***.***
전염병에 대한 구제는 지원도 복지도 아님 저 사람들이 자국민한테 퍼트리는걸 미연에 방지하는 사전조치일뿐이다 이걸 모르는 대갈텅텅이 존나존나존나 많아 진짜 ㅋㅋㅋ
(IP보기클릭)121.165.***.***
난 진짜 요즘 하루하루가 이문대인가 싶음 저게 세계최강국 미국의 선택이고 민낯이라고? ㄹㅇ? 이거 현실 맞나 | 25.03.11 20:32 | | |
(IP보기클릭)118.235.***.***
저새끼들은 본의아니게 우민화에 대성공을 해버려서...... 동아시아는 의도한 우민화라쳐도 저긴 참 신기하긴해 | 25.03.11 20:33 | | |
(IP보기클릭)121.171.***.***
(IP보기클릭)118.235.***.***
아쿠시즈교구장
미국인이 복지를 논한다고...? | 25.03.11 20:28 | | |
(IP보기클릭)122.32.***.***
(IP보기클릭)124.63.***.***
이런거 보니깐 진짜 미국애들이 많은걸 하고 있었네
(IP보기클릭)221.144.***.***
그러니까 줘까타도 세계경찰이다 뭐다 하면서 떠받들여준거지 | 25.03.11 20:29 | | |
(IP보기클릭)118.235.***.***
패권국이던 이유지 대체할 국가가 없는 이유기도 하고 쟤네는 단순히 군비만 존나 쓴게 아님 실제로 지지율도 고작2~3%(아직까진) 떨어진거 보면 진짜 저거에 '우리 세금 드디어 제대로 쓰네-!' 라고 생각하는 미국인들이 적지 않은 모양... | 25.03.11 20:29 | | |
(IP보기클릭)112.161.***.***
그런것들이 수십년간 쌓인것에 그걸 가능케하는 저력까지 포함해서 패권이란 단어로 불린거지 | 25.03.11 20:30 | | |
(IP보기클릭)118.235.***.***
(IP보기클릭)211.197.***.***
(IP보기클릭)220.116.***.***
(IP보기클릭)211.36.***.***
(IP보기클릭)221.144.***.***
(IP보기클릭)210.123.***.***
(IP보기클릭)118.235.***.***
껌둥이짱1깨 새끼 개지1랄 덕분에 트럼프도 이거봐라 내가 맞네란 확신에 일조하긴 했을듯 | 25.03.11 20:31 | | |
삭제된 댓글입니다.
(IP보기클릭)175.199.***.***
죄수-332326987
이미 5년 전에 그게 얼마나 힘들고 불가능에 가까운 일인지 이미 증명했음 | 25.03.11 20:31 | | |
(IP보기클릭)211.199.***.***
(IP보기클릭)175.199.***.***
(IP보기클릭)14.33.***.***
미국도 결핵 씰 생길테니 K-유행 좋았쓰!! …엣 이게 아닌가? -_- ㅂㄷㅂㄷ
(IP보기클릭)219.250.***.***
(IP보기클릭)175.198.***.***
(IP보기클릭)118.235.***.***
(IP보기클릭)121.190.***.***
(IP보기클릭)121.190.***.***
결국 감정적인 문제가 쌓여있던거에 WHO의 미친 짓이더해지면서 국제기구 자체에 대한 회의감도 컸겠지 | 25.03.11 20:38 | | |
(IP보기클릭)118.235.***.***
분담금도 제대로 안내면서 이래라 저래라 하는 유럽꼬라지 보면 빡이 칠만도 하고 실제로 느그끼리 알아서 하세요 스탠스기도 하고 | 25.03.11 20:39 | | |
(IP보기클릭)211.234.***.***
사실 이런면에서는 이해가기도함 유럽은 늘 잘난척 하면서 돈안내 군비 축소해 ㅎ | 25.03.11 20:42 | | |
(IP보기클릭)218.148.***.***
(IP보기클릭)222.118.***.***